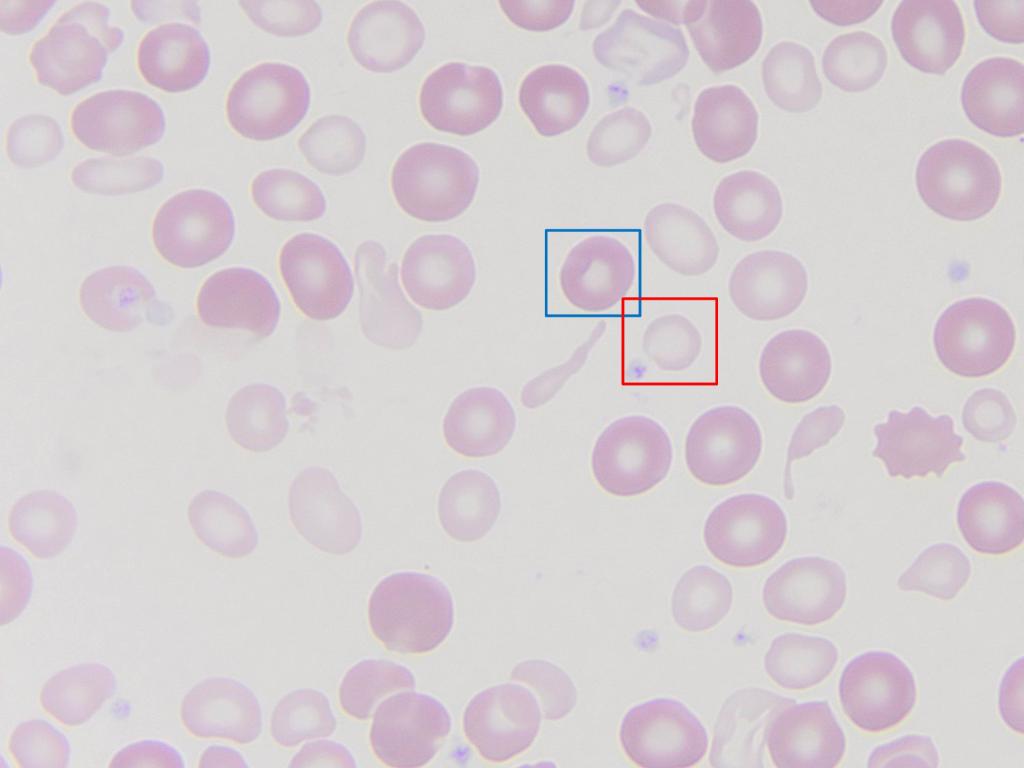
NCHforDocs's tweet image. #NCH_COTW The photomicrograph is from a stained peripheral blood smear from a patient with severe Iron deficiency anemia necessitating red blood cell (RBC) transfusion. What is the difference between the RBC in the red box and the one in the blue box? #PediPath #NCHPath

#nchpath ผลการค้นหา
Amazing!!! fantastic work (as usual) from @MArnold_PedPath and his amazing #NCHPath lab team! I will be using this for every #PathElective student and many #APCP PGY1s will benefit, and even non-Pathologist physicians too! Happy #LabWeek! @ASCP_Chicago @pathologistmag
We were inspired by #LabWeek! The #NCHpath lab made this 90 second video explaining how tissue is processed in the #pathology lab! Join me in thanking them for what they do everyday for our patients! #ASCPLabWeek19 #PediPath @NS4Histotech @ASCP_Chicago youtu.be/GJUjwEZxhv0
youtube.com
YouTube
Pathology tissue processing explained in 90 seconds
Happy #LabWeek2019 to #NCHpath team and lab professionals everywhere!
Our #LabWeek activity today is dress like your “pack”. The #NCHpath AP lab made themselves a box of crayons with some special #pathology colors! #ASCPLabWeek19 @ASCP_Chicago @NCHforDocs @KBadizad




#NCH_COTW Stained capillary vessel aspirated fairly intact. Arrows point to RBCs passing through lumens. Vascular lining cells stain blue. Blood cells go trillions of miles through narrow lumens of capillary vessels. #NCHPath #PediPath

Sunny days are (almost) here again! Can’t wait for the next picnic! #NCHpath #pedipath @MArnold_PedPath @jadeinthebubble

#NCH_COTW answer: The blue box contains a healthy transfused RBC. The red box contains the patient’s hypochromic (anemic), microcytic (smaller) RBC. #PediPath #NCHPath
Brilliant! Can't wait to see our entire grossing manual for #NCHpath in this format! Look forward to your course at #CAP19 @Pathologists
Got a #placenta and not much time? Learn to gross one in 90 seconds. Join @SCKoo80 and me for our course at #CAP19 to learn more! @Pathologists #Pedipath #GrossIn90 #NCHpath
What happens when cancer remission is in question? Should flow cytometry replace morphology for declaring remission of leukemia? spr.ly/6018DVh5w #NCHPath
Feeling inspired to make a how-to post! First, I am going to finish one project I know @KMirza is excited about. #PediPath #GrossIn90 #NCHpath
This photomicrograph is taken from stained cytospin prepared from pleural fluid of a patient who presented with fatigue and was found to have an anterior mediastinal mass. What is the cell in red circle? #PediPath #NCH_COTW #NCHPath

A new Children's Oncology Group study looks at outcomes for children with #leukemia when morphology and flow cytometry assessments of remission disagree. spr.ly/6012DnyVk #NCHPath
This photomicrograph was taken from the bone marrow aspirate of a patient who was found to have thrombocytopenia. What is the likely etiology? #NCHPath #PediPath #NCH_COTW

After a cluster of related papers, the mystery remains: What is the significance of these cytoplasmic aggregates? #GIpath #Pedipath #NCHpath @MArnold_PedPath @CArnold_GI
Now #EarlyOnline by Rose et al. Cytoplasmic Fibrillar Aggregates in Gallbladder Epithelium Are a Frequent Mimic of Cystoisospora in Pediatric Cholecystectomy Specimens. Free full text: buff.ly/2GgZgD6 #gipath #pedipath



Artificial Intelligence in Pathology: Friend or Foe? Whatever you answer, it's time to act. @Pathologists @MArnold_PedPath @DVanlandingham6 @wphampton #nchpath
Augmenting Pathology Labs With Big Data And Machine Learning Read more here: ift.tt/2I4s7YK #BigData #DataScience #MachineLearning #DeepLearning #NLP #Robots #AI #IoT
Congratulations to Dr. David Thornton for 39 years of outstanding service to @nationwidekids as clinical chemist and core lab/LIS director. Best wishes for a wonderful retirement! #NCHpath #pedipath @NCHforDocs @SusanDoud

Happy Histotechnology Professionals Day to the #NCHpath team and histotechs everywhere! @Pathologists #pedipath
Happy Histotechnology Professionals Day! Celebrating with H&E color cupcakes! 🔬@NCHforDocs #pathology #NCHpath #PediPath @KBadizad




And the answer is.... A Reed-Sternberg cell, which is (in the right microscopic background and clinical context) diagnostic of Hodgkin's lymphoma. The yellow circle contains a lymphocyte. #PediPath #NCH_COTW #NCHPath
“Poor data quality is enemy number one ...” as the @HarvardBiz review nicely articulates. Looking forward to the discussion of #AI in pathology @apcprods #apcprods2018 #NCHpath
Great article from @HarvardBiz on the importance of data quality, steps to keep quality high and how it affects machine learning. @KBadizad @wphampton #DataScience #ArtificialIntelligence #MachineLearning hbr.org/2018/04/if-you…
Want to learn the keys to grossing a #pedipath renal tumor in 90 seconds? Here’s an overview with new #NCHpath fellows @GaryRoseMD @HeidiReinhardMD! #GrossIn90 @NCHforDocs
Feeling inspired to make a how-to post! First, I am going to finish one project I know @KMirza is excited about. #PediPath #GrossIn90 #NCHpath
Here’s a great guide to #pathology hashtags from @Sara_Jiang. New #pathresident? Check it out: #NCHPath @NCHforDocs @OSUWexMed #PathEd #SocialMediaDay

My pocket #SoMe guide, both sides! NOT a comprehensive list of who to follow, just a start! #ASCP40underForty2017

Here we go! Lecturing and live tweeting about #SoMe in #pathology! #NCHPath #PathEd @NCHforDocs @OSUWexMed #SocialMediaDay

"Between 2007 and 2017, the number of active #pathologists in the United States decreased from 15 568 to 12 839 (−17.53%)." #pedipath #NCHpath @apcprods
Got a #placenta and not much time? Learn to gross one in 90 seconds. Join @SCKoo80 and me for our course at #CAP19 to learn more! @Pathologists #Pedipath #GrossIn90 #NCHpath
Amazing!!! fantastic work (as usual) from @MArnold_PedPath and his amazing #NCHPath lab team! I will be using this for every #PathElective student and many #APCP PGY1s will benefit, and even non-Pathologist physicians too! Happy #LabWeek! @ASCP_Chicago @pathologistmag
We were inspired by #LabWeek! The #NCHpath lab made this 90 second video explaining how tissue is processed in the #pathology lab! Join me in thanking them for what they do everyday for our patients! #ASCPLabWeek19 #PediPath @NS4Histotech @ASCP_Chicago youtu.be/GJUjwEZxhv0
youtube.com
YouTube
Pathology tissue processing explained in 90 seconds
We were inspired by #LabWeek! The #NCHpath lab made this 90 second video explaining how tissue is processed in the #pathology lab! Join me in thanking them for what they do everyday for our patients! #ASCPLabWeek19 #PediPath @NS4Histotech @ASCP_Chicago youtu.be/GJUjwEZxhv0
youtube.com
YouTube
Pathology tissue processing explained in 90 seconds
Happy #LabWeek2019 to #NCHpath team and lab professionals everywhere!
Our #LabWeek activity today is dress like your “pack”. The #NCHpath AP lab made themselves a box of crayons with some special #pathology colors! #ASCPLabWeek19 @ASCP_Chicago @NCHforDocs @KBadizad




Our #LabWeek activity today is dress like your “pack”. The #NCHpath AP lab made themselves a box of crayons with some special #pathology colors! #ASCPLabWeek19 @ASCP_Chicago @NCHforDocs @KBadizad




Celebrating #LabWeek with an educational display about what happens in the lab, and prizes! Great job Kay, Cassidy and Veronica!#NCHpath @ASCP_Chicago


#NCH_COTW Stained capillary vessel aspirated fairly intact. Arrows point to RBCs passing through lumens. Vascular lining cells stain blue. Blood cells go trillions of miles through narrow lumens of capillary vessels. #NCHPath #PediPath

Representative H&E stained section and Giemsa stained touch imprints of a lymph node excised from this 6-year-old boy with massive cervical lymphadenopathy - What is your diagnosis? #NCHPath #PediPath #NCH_COTW

#NCH_COTW The photomicrograph is from a stained peripheral blood smear from a patient with severe Iron deficiency anemia necessitating red blood cell (RBC) transfusion. What is the difference between the RBC in the red box and the one in the blue box? #PediPath #NCHPath
The Image is from a stool preparation of a child with diarrhea. What are the circled objects?#NCH_COTW #PediPath #NCHPath

Happy Happy Histology Professionals Day! Celebrating with the #NCHpath lab in their newest T-shirts! #PediPath #Pathology @NS4Histotech #HPD #NSH #histology



Happy Valentines Day! Roses are sometimes red Violets are sometimes blue #NCHPath always wishes a Happy Valentine's Day to you! Look for new editions of #NCH_COTW coming to a Twitter feed near you. #PediPath #MedTwitterValentines

This photomicrograph was taken from the bone marrow aspirate of a patient who was found to have thrombocytopenia. What is the likely etiology? #NCHPath #PediPath #NCH_COTW

This photomicrograph was taken from the bone marrow aspirate of a 12-year-old child who was found to have thrombocytopenia. What is the likely etiology? #NCHPath #PediPath #NCH_COTW

A resected terminal ileum of a 5 month-old female presenting with abdominal pain and bloody stool. What is your diagnosis? What pathologic processes can predispose to this condition? #NCHPath #PediPath #NCH_COTW

Any #Hemepath tweeps seen this happen? Radio frequency interference with a hematology analyzer caused by a cell phone relay. Look at side scatter on control beads with the antenna power up! #NCHpath #pedipath @hematogones @kmirza doi.org/10.1093/ajcp/a…


This ultrastructure (electron microscopy) image is taken from a skin biopsy of an 11 month old child with a rash. What is the likely diagnosis? #NCHPath #PediPath #NCH_COTW

This photomicrograph is taken from stained cytospin prepared from pleural fluid of a patient who presented with fatigue and was found to have an anterior mediastinal mass. What is the cell in red circle? #PediPath #NCH_COTW #NCHPath

Dr. Rachel Mariani from Nationwide Children's presents her work done at Lurie Children's on Cbl/Ras pathway mutations in juvenile myelomonocytic leukemia. #USCAP2019 #nchpath


Sunny days are (almost) here again! Can’t wait for the next picnic! #NCHpath #pedipath @MArnold_PedPath @jadeinthebubble

Wonderful to have @kmirza visit us! Excellent talks and so nice to hang out again in real life. Thanks @CArnold_GI and #OSUPSIG for bringing him to Columbus! #PSIG #NCHpath


He made it to Columbus! Such a great time catching up with @kmirza in real life! #NCHpath #OSUPSIG. @KBadizad @WendyFrankelMD @CArnold_GI

Here’s a great guide to #pathology hashtags from @Sara_Jiang. New #pathresident? Check it out: #NCHPath @NCHforDocs @OSUWexMed #PathEd #SocialMediaDay

My pocket #SoMe guide, both sides! NOT a comprehensive list of who to follow, just a start! #ASCP40underForty2017

Celebrating #LabWeek with an educational display about what happens in the lab, and prizes! Great job Kay, Cassidy and Veronica!#NCHpath @ASCP_Chicago


Something went wrong.
Something went wrong.
United States Trends
- 1. Artemis II N/A
- 2. April Fools N/A
- 3. Constitution N/A
- 4. T-10 N/A
- 5. Cam Schlittler N/A
- 6. Supreme Court N/A
- 7. Passover N/A
- 8. SCOTUS N/A
- 9. 14th Amendment N/A
- 10. Justin Crawford N/A
- 11. Pumpernickel N/A
- 12. FULL SEND N/A
- 13. Chag Sameach N/A
- 14. Chag Pesach Sameach N/A
- 15. Skubal N/A
- 16. Hurts N/A
- 17. Lindor N/A
- 18. Shenanigans N/A
- 19. T-minus 10 N/A
- 20. Challenger N/A













